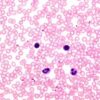

Aluminium test Merck
0 ₫
Bộ thuốc thuốc thử Aluminium của Merck chuyên dùng để thử nghiệm đo các ion nhôm trong nước ngầm và nước mặt, nước biển, nước uống và nước hồ cá. Bộ kiểm tra có chứa thẻ màu dễ sử dụng.
| Tên sản phẩm: | Aluminium test Merck |
| Code: | 1144130001 |
| Hãng-Xuất xứ: | Merck-Đức |
| Ứng dụng: | Thử nghiệm đo các ion nhôm trong nước ngầm và nước mặt, nước biển, nước uống và nước hồ cá. Ứng dung phổ biến trong các phòng thí nghiệm môi trường, trong nuôi cấy thủy hải sản… |
| Thông số sản phẩm: |
– Phương pháp: Đo bằng thẻ màu, dễ dàng sử dụng – So màu với các nồng độ: 0,07 – 0,12 – 0,20 – 0,35 – 0,50 – 0,65 – 0,80 mg / l – Bảo quản +15°C đến +25°C. – Quy cách đóng gói: Hộp/185 test |
Hãy là người đầu tiên nhận xét “Aluminium test Merck” Hủy
Sản phẩm tương tự
Hóa chất thí nghiệm
CAL Check™ chuẩn Clo thang cao, 0.00 và 4.00 mg/L HI96734-11 Hanna
Hóa chất thí nghiệm
Titriplex® III solution for 1000 ml, c(Na₂-EDTA 2 H₂O) = 0.01 mol/l Titrisol®
Hóa chất thí nghiệm
Potassium iodate solution for 1000 ml, c(KIO₃) = 1/₆₀ mol/l (0.1 N) Titrisol®
Hóa chất thí nghiệm
Hóa chất thí nghiệm
Hóa chất thí nghiệm
Hóa chất thí nghiệm
Hóa chất thí nghiệm

Đánh giá
Chưa có đánh giá nào.